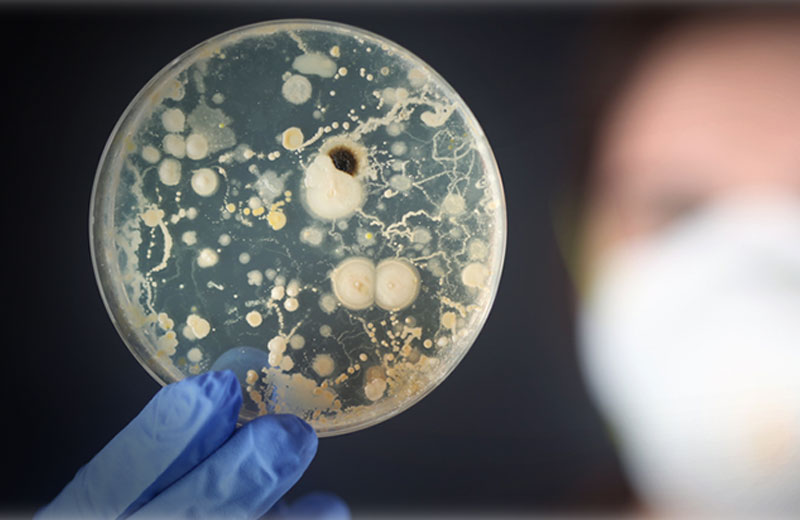
Foto: reprodução / History

Bactéria probiótica pode prolongar vida até os 120 anos
Longevidade com qualidade de vida! Cientistas da Argentina conseguiram provar que uma bactéria pode previnir doenças e retardar o envelhecimento.
É a bactéria probiótica Bacillus subtilis. Ela é consumida há milhares de anos, especialmente em países asiáticos, onde a longevidade média é acima da média mundial.
Embora seus efeitos fossem conhecidos, somente agora eles puderam ser pesquisados em vermes nematódeos Caenorhabditis elegans, que possuem as mesmas enzimas regulatórias dos seres humanos.
A descoberta é de especialistas da Universidade Nacional de Rosário e do CONICET (Consejo Nacional de Investigaciones Científicas y Técnicas), da Argentina.
120 anos
Roberto Grau, responsável pela pesquisa, explicou que essa bactéria, além de prolongar a vida do nematódeo, também mantém sua vitalidade.
“Isso, em seres humanos, significaria uma vida além dos 120 anos, com a vitalidade de uma pessoa de 50”, afirmou.
A bactéria
Diferentemente de outras bactérias, esse probiótico não necessita de refrigeração para manter seus efeitos positivos.
“Além disso, tem a particularidade de gerar um tipo de célula altamente resistente chamada esporo que, depois de consumida, germina e dá origem a bactérias probióticas ativas, as quais produzem efeitos benéficos”, acrescentou o especialista.
Um dos pontos fortes que a pesquisa mostrou é que essas bactérias podem ser incorporadas tanto em comidas quanto em bebidas, sem inconveniente, mas ainda teremos que esperar pelo processo para permitir sua inclusão como um aditivo alimentar”, alertou o pesquisador.
Com informações do History e TodoCiencia

 Médicos brasileiros fazem cirurgia inédita e salvam recém-nascida com problema congênito no coração
Médicos brasileiros fazem cirurgia inédita e salvam recém-nascida com problema congênito no coração Remédio contra colesterol reduz risco de infarto em 30%, revela estudo
Remédio contra colesterol reduz risco de infarto em 30%, revela estudo Vitamina B3 pode reverter gordura no fígado, descobrem cientistas
Vitamina B3 pode reverter gordura no fígado, descobrem cientistas Primeiro porco clonado no Brasil nasce em SP e pode salvar milhares de vidas humanas
Primeiro porco clonado no Brasil nasce em SP e pode salvar milhares de vidas humanas Exame de sangue brasileiro que detecta câncer de mama em estágio inicial chegará ao SUS
Exame de sangue brasileiro que detecta câncer de mama em estágio inicial chegará ao SUS Mounjaro em pílula é aprovado nos EUA; chega de injeção
Mounjaro em pílula é aprovado nos EUA; chega de injeção Coelhinho resgatado aprende a jogar Jenga e vira campeão; vídeo
Coelhinho resgatado aprende a jogar Jenga e vira campeão; vídeo Tratamento contra câncer de mama que não cai cabelo já está disponível no SUS
Tratamento contra câncer de mama que não cai cabelo já está disponível no SUS Homem que vive na rua escreve bilhete pedindo ajuda para tratar cachorrinho doente… e consegue
Homem que vive na rua escreve bilhete pedindo ajuda para tratar cachorrinho doente… e consegue Mulher “adota” idosa viúva que mudou de cidade sozinha: “anjos existem”
Mulher “adota” idosa viúva que mudou de cidade sozinha: “anjos existem” “Deus salvou a gente”, diz motorista de carro atingido por árvore durante tempestade
“Deus salvou a gente”, diz motorista de carro atingido por árvore durante tempestade Menino de 8 anos comemora vitória contra o câncer dançando e dando pirueta; video
Menino de 8 anos comemora vitória contra o câncer dançando e dando pirueta; video